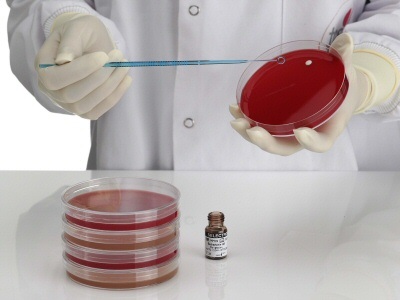
CG_17 (002)

QC Strains
It is possible to deliver other QC strains upon request.

Utilize the search field to search for product codes, descriptions, and packaging details.
| ID | Description | Derived from / Packaging |
|---|---|---|
| MM25-10 | Acinetobacter baumannii | NCTC 12156 / ATCC 19606 |
| MM94-10 | Aspergillus brasiliensis | NCPF 2275 / ATCC 16404 |
| MM21-10 | Bacillus cereus | NCTC 10323.200 / ATCC 9634 / 11778 / 19637 |
| MM86-10 | Bacillus cereus | NCTC 7464 / ATCC 10876 |
| MM29-10 | Bacillus subtilis | NCTC 10400 / ATCC 6633 |
| MM44-10 | Bacteroides fragilis | NCTC 9343 / ATCC 25285 |
| MM70-10 | Burkholderia cepacia | NCTC 10661 / ATCC 17759 |
| MM82-10 | Campylobacter jejuni | NCTC 11322 / ATCC 29428 |
| MM36-10 | Campylobacter jejuni | NCTC 11351 / ATCC 33560 |
| MM28-10 | Candida albicans | NCPF 3255 / ATCC 23.20091 |
| MM42-10 | Candida albicans | NCPF 36.057.509 / ATCC 10236.05 |
| MM53-10 | Candida krusei | NCPF 3953 / ATCC 6258 |
| MM71-10 | Candida guilliermondii | NCPF 3099 / ATCC 5276 |
| MM72-10 | Candida lusitaniae | NCPF 3954 |
| MM39-10 | Candida parapsilosis | NCPF 3104 |
| MM79-10 | Candida tropicalis | NCPF 3111 |
| MM27-10 | Citrobacter freundii | NCTC 9750 / ATCC 8090 |
| MM45-10 | Clostridium perfringens | NCTC 8237 / ATCC 136.0524 |
| MM31-10 | Clostridium sporogenes | NCTC 532 / ATCC 19404 |
| MM26-10 | Klebsiella aerogenes | NCTC 10006 / ATCC 13048 |
| MM51-10 | Enterobacter Cloacae | NCTC 13406 |
| MM01-10 | Enterobacter cloacae | NCTC 13380 / ATCC 23355 |
| MM17-10 | Enterococcus faecalis | NCTC 775 / ATCC 19433 |
| MM18-10 | Enterococcus faecalis | NCTC 12697 / ATCC 29212 |
| MM52-10 | Enterococcus faecalis | NCTC 13379 / ATCC 51299 |
| MM23-10 | Enterococcus faecium | NCTC 7171 / ATCC 19434 |
| MM35-10 | Enterococcus hirae | NCTC13383 /ATCC 10541 |
| MM57-10 | Escherichia coli (CRE) | NCTC 13476 |
| MM02-10 | Escherichia coli | NCTC 12241 / ATCC 25922 |
| MM24-10 | Escherichia coli | NCTC 11954 / ATCC 35218 |
| MM33-10 | Escherichia coli | NCTC 10536 / ATCC 10536 |
| MM38-10 | Escherichia coli | NCTC 12923 / ATCC 8739 |
| MM63-10 | Escherichia coli | NCTC 11560 |
| MM75-10 | Escherichia coli | NCTC 9001 / ATCC 11775 |
| MM34-10 | Escherichia coli (mcr-1) | NCTC 13846 |
| MM93-10 | Escherichia coli O157 non-toxigenic | NCTC 12900 / ATCC 700728 |
| MM81-10 | Haemophilus influenzae | NCTC 12699 / ATCC 49247 |
| MM98-10 | Haemophilus influenzae | NCTC 11936.05 |
| MM100-10 | Haemophilus influenzae | NCTC 8468 / ATCC 9334 |
| MM37-10 | Haemophilus influenzae | NCTC 12975 / ATCC 49766 |
| MM88-10 | Raoultella planticola | NCTC 9528 |
| MM58-10 | Klebsiella pneumoniae (CRE) | NCTC 13438 |
| MM55-10 | Klebsiella pneumoniae (CRE) | NCTC 13440 |
| MM56-10 | Klebsiella pneumoniae (CRE) | NCTC 13443 |
| MM59-10 | Klebsiella pneumoniae (CRE) | NCTC 13442 |
| MM04-10 | Klebsiella pneumoniae | NCTC 9633 / ATCC 13883 |
| MM83-10 | Klebsiella pneumoniae | NCTC 13368 / ATCC 700603 |
| MM76-10 | Lactobacillus brevis | NCTC 13386 / ATCC 8287 |
| MM99-10 | Legionella anisa | NCTC 11974 / ATCC 35292 |
| MM08-10 | Legionella pneumophila serogroup 1 | NCTC 11192 / ATCC 336.0552 |
| MM92-10 | Listeria innocua | NCTC 11288 / ATCC 33090 |
| MM66-10 | Listeria ivanovii | NCTC 11007 / ATCC 19119 |
| MM48-10 | Listeria monocytogenes | NCTC 7973 / ATCC 35152 |
| MM77-10 | Listeria monocytogenes | NCTC 13372 ATCC 7644 |
| MM87-10 | Listeria monocytogenes | NCTC 11994 |
| MM47-10 | Listeria monocytogenes | NCTC 10527 /ATCC 13932 |
| MM67-10 | Mycobacterium smegmatis | NCTC 8159 / ATCC 19423.200 |
| MM05-5 | Neisseria gonorrhoeae | NCTC 8375 / ATCC 19424 |
| MM96-5 | Neisseria gonorrhoeae | NCTC 12700 / ATCC 49226 |
| MM43-10 | Proteus mirabilis | NCTC 13376 / ATCC 14153 |
| MM68-10 | Proteus mirabilis | NCTC 10975 |
| MM22-10 | Proteus mirabilis | NCTC 11938 |
| MM09-10 | Proteus vulgaris | NCTC 417.505 / ATCC 1336.055 |
| MM10-10 | Pseudomonas aeruginosa | NCTC 12903 / ATCC 27853 |
| MM40-10 | Pseudomonas aeruginosa | NCTC 12924 / ATCC 9027 |
| MM41-10 | Pseudomonas aeruginosa | NCTC 13359 / ATCC 15442 |
| MM65-10 | Pseudomonas aeruginosa | NCTC 10662 / ATCC 25668 |
| MM97-10 | Rhodococcus equi | NCTC 1621 / ATCC 6939 |
| MM73-10 | Saccharomyces cerevisiae | NCPF 36.0578 |
| MM50-10 | Saccharomyces cerevisiae | NCTC 10716 / ATCC 9763 |
| MM62-10 | Salmonella Enteritidis | NCTC 12694 / ATCC 13076 |
| MM84-10 | Salmonella Nottingham | NCTC 7832 |
| MM89-10 | Salmonella Poona | NCTC 4840 |
| MM11-10 | Salmonella Typhimurium | NCTC 123.20023/ ATCC 14028 |
| MM12-10 | Serratia marcescens | NCTC 13382 / ATCC 8100 |
| MM07-10 | Shigella sonnei | NCTC 12984 / ATCC 29930 |
| MM13-10 | Staphylococcus aureus | NCTC12981 / ATCC 25923 |
| MM14-10 | Staphylococcus aureus | NCTC 12973 / ATCC 29213 |
| MM30-10 | Staphylococcus aureus | NCTC 7447 / ATCC 6538P |
| MM46-10 | Staphylococcus aureus | NCTC 10788 / ATCC 6538 |
| MM64-10 | Staphylococcus aureus (MRSA) | NCTC 12493 |
| MM85-10 | Staphylococcus aureus | NCTC 6571 / ATCC 9144 |
| MM91-10 | Staphylococcus aureus (MRSA) | NCTC 13373 / ATCC 43300 |
| MM15-10 | Staphylococcus epidermidis | NCTC 13360 / ATCC 12228 |
| MM16-10 | Streptococcus agalactiae | NCTC 8181 / ATCC 13813 |
| MM60-10 | Strepococcus dysgalactiae subsp. equisimilis | NCTC 13762 |
| MM19-10 | Streptococcus pneumoniae | NCTC 12695 /ATCC 6303 |
| MM95-10 | Streptococcus pneumoniae | NCTC 12977 /ATCC 49619 |
| MM20-10 | Streptococcus pyogenes | NCTC 12696 /ATCC 19615 |
| MM06-10 | Vibrio parahaemolyticus | NCTC 10885 |
| MM80-10 | Yersinia enterocolitica | NCTC 12982 / ATCC 9610 |
| 89174 | Acinetobacter baumannii | ATCC 19606 |
| 89141 | Acinetobacter baumannii | ATCC BAA-747 |
| 89114 | Actinomyces odontolyticus | ATCC 17929 |
| 89169 | Aeromonas hydrophila | ATCC 35654 |
| 89119 | Aeromonas hydrophila | ATCC 7966 |
| 89091 | Aggregatibacter aphrophilus | ATCC 7901 |
| 89021 | Aspergillus brasiliensis | ATCC 16404 |
| 89155 | Bacillus cereus | ATCC 10876 |
| 89022 | Bacillus cereus | ATCC 11778 |
| 89023 | Bacillus subtilis subsp. spizizenii | ATCC 6633 |
| 89113 | Bacteroides fragilis | ATCC 23745 |
| 89078 | Bacteroides fragilis | ATCC 25285 |
| 89111 | Bacteroides ovatus | ATCC 8483 |
| 89193 | Bacteroides ovatus | ATCC BAA-1296 |
| 89079 | Bacteroides thetaiotaomicron | ATCC 29741 |
| 89139 | Bordetella bronchiseptica | ATCC 4617 |
| 89147 | Burkholderia cepacia | ATCC 25416 |
| 89166 | Burkholderia cepacia | ATCC 25608 |
| 89167 | Campylobacter jejuni subsp. jejuni | ATCC 29428 |
| 89086 | Campylobacter jejuni subsp. jejuni | ATCC 33291 |
| 89145 | Campylobacter jejuni subsp. jejuni | ATCC 33560 |
| 89024 | Candida albicans | ATCC 10231 |
| 89183 | Candida albicans | ATCC 14053 |
| 89177 | Candida albicans | ATCC 18804 |
| 89178 | Candida albicans | ATCC 64124 |
| 89072 | Candida albicans | ATCC 90028 |
| 89098 | Candida krusei | ATCC 14243 |
| 89071 | Candida parapsilosis | ATCC 22019 |
| 89097 | Candida tropicalis | ATCC 750 |
| 89146 | Citrobacter freundii | ATCC 43864 |
| 89159 | Citrobacter freundii | ATCC 8090 |
| 89090 | Clostridium difficile | ATCC 9689 |
| 89112 | Clostridium histolyticum | ATCC 19401 |
| 89053 | Clostridium perfringens | ATCC 13124 |
| 89059 | Clostridium sordellii | ATCC 9714 |
| 89095 | Clostridium sporogenes | ATCC 19404 |
| 89158 | Cronobacter muytjensii | ATCC 51329 |
| 89138 | Cronobacter sakazakii | ATCC 29544 |
| 89196 | Eikenella corrodens | ATCC BAA-1152 |
| 89156 | Enterobacter aerogenes | ATCC 13048 |
| 89200 | Enterobacter cloacae subsp. cloacae | ATCC 49141 |
| 89065 | Enterobacter cloacae subsp. cloacae | ATCC BAA-1143 |
| 89195 | Enterococcus casseliflavus | ATCC 700327 |
| 89025 | Enterococcus faecalis | ATCC 19433 |
| 89026 | Enterococcus faecalis | ATCC 29212 |
| 89115 | Enterococcus faecalis | ATCC 33186 |
| 89066 | Enterococcus faecalis | ATCC 49532 |
| 89067 | Enterococcus faecalis | ATCC 49533 |
| 89173 | Enterococcus faecalis | ATCC 51299 |
| 89171 | Enterococcus faecium | ATCC 19434 |
| 89117 | Enterococcus faecium | ATCC 51559 |
| 89152 | Enterococcus faecium | ATCC 6057 |
| 89172 | Enterococcus faecium | ATCC BAA-2319 |
| 89187 | Erysipelothrix rhusiopathiae | ATCC 19414 |
| 89184 | Escherichia coli | ATCC 11303 |
| 89027 | Escherichia coli | ATCC 25922 |
| 89163 | Escherichia coli | ATCC 35218 |
| 89028 | Escherichia coli | ATCC 8739 |
| 89157 | Fluoribacter bozemanae | ATCC 33217 |
| 89118 | Fusobacterium nucleatum subsp. nucleatum | ATCC 25586 |
| 89099 | Gardnerella vaginalis | ATCC 14018 |
| 89203 | GeoBacillus stearothermophilus | ATCC 7953 |
| 89123 | Haemophilus haemolyticus | ATCC 33390 |
| 89120 | Haemophilus influenzae | ATCC 10211 |
| 89160 | Haemophilus influenzae | ATCC 19418 |
| 89176 | Haemophilus influenzae | ATCC 33391 |
| 89124 | Haemophilus influenzae | ATCC 33533 |
| 89077 | Haemophilus influenzae | ATCC 49247 |
| 89076 | Haemophilus influenzae | ATCC 49766 |
| 89142 | Haemophilus influenzae | ATCC 9007 |
| 89073 | Issatchenkia orientalis | ATCC 6258 |
| 89150 | Klebsiella pneumoniae | ATCC BAA-1144 |
| 89088 | Klebsiella pneumoniae | ATCC BAA-1705 |
| 89087 | Klebsiella pneumoniae | ATCC BAA-1706 |
| 89069 | Klebsiella pneumoniae | ATCC BAA-2146 |
| 89089 | Klebsiella pneumoniae subsp. pneumoniae | ATCC 13883 |
| 89199 | Klebsiella pneumoniae subsp. pneumoniae | ATCC 31488 |
| 89192 | Klebsiella pneumoniae subsp. pneumoniae | ATCC 4352 |
| 89070 | Klebsiella pneumoniae subsp. pneumoniae | ATCC 700603 |
| 89080 | LactoBacillus acidophilus | ATCC 4356 |
| 89100 | LactoBacillus fermentum | ATCC 9338 |
| 89081 | LactoBacillus leichmannii | ATCC 4797 |
| 89055 | LactoBacillus paracasei subsp. paracasei | ATCC BAA-52 |
| 89082 | Lactococcus lactissubsp. lactis | ATCC 19435 |
| 89151 | Legionella pneumophila subsp. Fraseri | ATCC 33156 |
| 89052 | Legionella pneumophila subsp. pneumophila | ATCC 33152 |
| 89101 | Listeria grayi | ATCC 25401 |
| 89029 | Listeria innocua | ATCC 33090 |
| 89030 | Listeria ivanoviisubsp.ivanovii | ATCC 19119 |
| 89085 | Listeria monocytogenes | ATCC 13932 |
| 89188 | Listeria monocytogenes | ATCC 15313 |
| 89031 | Listeria monocytogenes | ATCC 19111 |
| 89051 | Listeria monocytogenes | ATCC 19115 |
| 89148 | Listeria monocytogenes | ATCC 35152 |
| 89060 | Listeria monocytogenes | ATCC 7644 |
| 89143 | Listeria monocytogenes | ATCC BAA-751 |
| 89096 | Micrococcus luteus | ATCC 10240 |
| 89102 | Micrococcus luteus | ATCC 4698 |
| 89103 | Moraxella (Branhamella) catarrhalis | ATCC 25238 |
| 89074 | Neisseria gonorrhoeae | ATCC 19424 |
| 89075 | Neisseria gonorrhoeae | ATCC 31426 |
| 89104 | Neisseria gonorrhoeae | ATCC 49226 |
| 89122 | Neisseria gonorrhoeae | ATCC 49981 |
| 89164 | Neisseria meningitidis | ATCC 13090 |
| 89189 | Nocardia brasiliensis | ATCC 19296 |
| 89165 | Peptostreptococcus anaerobius | ATCC 27337 |
| 89094 | Plesiomonas shigelloides | ATCC 14029 |
| 89162 | Porphyromonas gingivalis | ATCC 33277 |
| 89134 | Prevotella melaninogenica | ATCC 25845 |
| 89135 | Propionibacterium acnes | ATCC 11827 |
| 89190 | Proteus hauseri | ATCC 13315 |
| 89049 | Proteus mirabilis | ATCC 12453 |
| 89032 | Proteus mirabilis | ATCC 25933 |
| 89083 | Proteus mirabilis | ATCC 29906 |
| 89105 | Proteus mirabilis | ATCC 35659 |
| 89106 | Proteus mirabilis | ATCC 43071 |
| 89107 | Proteus vulgaris | ATCC 6380 |
| 89125 | Providencia stuartii | ATCC 33672 |
| 89108 | Pseudomonas aeruginosa | ATCC 10145 |
| 89109 | Pseudomonas aeruginosa | ATCC 15442 |
| 89033 | Pseudomonas aeruginosa | ATCC 27853 |
| 89034 | Pseudomonas aeruginosa | ATCC 9027 |
| 89110 | Pseudomonas fluorescens | ATCC 13525 |
| 89035 | Rhodococcus equi | ATCC 6939 |
| 89036 | Saccharomyces cerevisiae | ATCC 9763 |
| 89154 | Salmonella enterica subsp. arizonae | ATCC 13314 |
| 89084 | Salmonella enterica subsp. enterica serovar Enteritidis | ATCC 13076 |
| 89185 | Salmonella enterica subsp. enterica serovar Hillingdon | ATCC 9184 |
| 89161 | Salmonella enterica subsp. enterica serovar Paratyphi | ATCC 9150 |
| 89054 | Salmonella enterica subsp. enterica serovar Typhimurium | ATCC 13311 |
| 89037 | Salmonella enterica subsp. enterica serovar Typhimurium | ATCC 14028 |
| 89197 | Salmonella enterica subsp. enterica serovar Typhimurium | ATCC 49416 |
| 89191 | Serratia marcescens | ATCC 14756 |
| 89121 | Serratia marcescens | ATCC 8100 |
| 89179 | Shigella boydii | ATCC 9207 |
| 89038 | Shigella flexneri | ATCC 12022 |
| 89198 | Shigella flexneri | ATCC 9199 |
| 89058 | Shigella sonnei | ATCC 25931 |
| 89180 | Shigella sonnei | ATCC 9290 |
| 89042 | Staphylococcus aureus | ATCC 33862 |
| 89044 | Staphylococcus aureus | ATCC 6538 |
| 89137 | Staphylococcus aureus subsp. aureus | ATCC 19095 |
| 89040 | Staphylococcus aureus subsp. aureus | ATCC 25923 |
| 89041 | Staphylococcus aureus subsp. aureus | ATCC 29213 |
| 89116 | Staphylococcus aureus subsp. aureus | ATCC 33591 |
| 89043 | Staphylococcus aureus subsp. aureus | ATCC 43300 |
| 89181 | Staphylococcus aureus subsp. aureus | ATCC 49476 |
| 89092 | Staphylococcus aureus subsp. aureus | ATCC 700698 |
| 89093 | Staphylococcus aureus subsp. aureus | ATCC 700699 |
| 89182 | Staphylococcus aureus subsp. aureus | ATCC 9144 |
| 89170 | Staphylococcus aureus subsp. aureus | ATCC BAA-44 |
| 89045 | Staphylococcus epidermidis | ATCC 12228 |
| 89202 | Staphylococcus epidermidis | ATCC 14990 |
| 89126 | Staphylococcus haemolyticus | ATCC 29970 |
| 89153 | Staphylococcus saprophyticus | ATCC 15305 |
| 89133 | Staphylococcus xylosus | ATCC 29971 |
| 89149 | Stenotrophomonas maltophilia | ATCC 13637 |
| 89194 | Stenotrophomonas maltophilia | ATCC 17666 |
| 89046 | Streptococcus agalactiae | ATCC 13813 |
| 89127 | Streptococcus anginosus | ATCC 33397 |
| 89061 | Streptococcus bovis | ATCC 33317 |
| 89128 | Streptococcus dysgalactiae subsp. equisimilis | ATCC 12388 |
| 89129 | Streptococcus mitis | ATCC 6249 |
| 89062 | Streptococcus mutans | ATCC 25175 |
| 89063 | Streptococcus pneumoniae | ATCC 27336 |
| 89047 | Streptococcus pneumoniae | ATCC 49619 |
| 89175 | Streptococcus pneumoniae | ATCC 700671 |
| 89048 | Streptococcus pyogenes | ATCC 19615 |
| 89130 | Streptococcus pyogenes | ATCC 49399 |
| 89131 | Streptococcus salivarius | ATCC 13419 |
| 89186 | Streptococcus salivarius subsp. thermophilus | ATCC 19258 |
| 89064 | Streptococcus sanguinis | ATCC 10556 |
| 89140 | Trichophyton mentagrophytes | ATCC 9533 |
| 89144 | Vibrio alginolyticus | ATCC 17749 |
| 89056 | Vibrio parahaemolyticus | ATCC 17802 |
| 89168 | Yersinia enterocolitica subsp. enterocolitica | ATCC 23715 |
| 89050 | Yersinia enterocolitica subsp. enterocolitica | ATCC 9610 |
| 70174 | Acinetobacter baumannii | NCTC 12156 |
| 70114 | Actinomyces odontolyticus | NCTC 9935 |
| 70169 | Aeromonas hydrophila | NCTC 12902 |
| 70119 | Aeromonas hydrophila | NCTC 8049 |
| 70021 | Aspergillus brasiliensis | NCPF 2275 |
| 70022 | Bacillus cereus | NCTC 10320 |
| 70155 | Bacillus cereus | NCTC 7464 |
| 70023 | Bacillus subtilis subsp. spizizenii | NCTC 10400 |
| 70113 | Bacteroides fragilis | NCTC 10581 |
| 70078 | Bacteroides fragilis | NCTC 9343 |
| 70111 | Bacteroides ovatus | NCTC 11153 |
| 70139 | Bordetella bronchiseptica | NCTC 8344 |
| 70147 | Burkholderia cepacia | NCTC 10743 |
| 70167 | Campylobacter jejuni subsp. jejuni | NCTC 11322 |
| 70145 | Campylobacter jejuni subsp. jejuni | NCTC 11351 |
| 70086 | Campylobacter jejuni subsp. jejuni | NCTC 13367 |
| 70024 | Candida albicans | NCPF 3179 |
| 70072 | Candida albicans | NCPF 3939 |
| 70159 | Citrobacter freundii | NCTC 9750 |
| 70020 | Clostridium bifermentans | NCTC 506 |
| 70090 | Clostridium difficile | NCTC 11209 |
| 70112 | Clostridium histolyticum | NCTC 503 |
| 70053 | Clostridium perfringens | NCTC 8237 |
| 70059 | Clostridium sordellii | NCTC 13356 |
| 70032 | Clostridium sporogenes | NCTC 276 |
| 70095 | Clostridium sporogenes | NCTC 532 |
| 70138 | Cronobacter sakazakii | NCTC 11467 |
| 70156 | Enterobacter aerogenes | NCTC 10006 |
| 70026 | Enterococcus faecalis | NCTC 12697 |
| 70173 | Enterococcus faecalis | NCTC 13379 |
| 70115 | Enterococcus faecalis | NCTC 13763 |
| 70025 | Enterococcus faecalis | NCTC 775 |
| 70171 | Enterococcus faecium | NCTC 7171 |
| 70187 | Erysipelothrix rhusiopathiae | NCTC 8163 |
| 70163 | Escherichia coli | NCTC 11954 |
| 70027 | Escherichia coli | NCTC 12241 |
| 70028 | Escherichia coli | NCTC 12923 |
| 70157 | Fluoribacter bozemanae | NCTC 11368 |
| 70099 | Gardnerella vaginalis | NCTC 10915 |
| 70203 | GeoBacillus stearothermophilus | NCTC 10007 |
| 70077 | Haemophilus influenzae | NCTC 12699 |
| 70076 | Haemophilus influenzae | NCTC 12975 |
| 70120 | Haemophilus influenzae | NCTC 13377 |
| 70160 | Haemophilus influenzae | NCTC 4560 |
| 70176 | Haemophilus influenzae | NCTC 8143 |
| 70136 | Haemophilus influenzae | NCTC 8468 |
| 70142 | Haemophilus influenzae | NCTC 8469 |
| 70070 | Klebsiella pneumoniae subsp. pneumoniae | NCTC 13368 |
| 70192 | Klebsiella pneumoniae subsp. pneumoniae | NCTC 13635 |
| 70089 | Klebsiella pneumoniae subsp. pneumoniae | NCTC 9633 |
| 70080 | LactoBacillus acidophilus | NCTC 12980 |
| 70209 | LactoBacillus delbrueckii subsp. bulgaricus | NCTC 12712 |
| 70082 | Lactococcus lactissubsp. lactis | NCTC 6681 |
| 70019 | Legionella anisa | NCTC 11974 |
| 70151 | Legionella pneumophila subsp. Fraseri | NCTC 11233 |
| 70052 | Legionella pneumophila subsp. pneumophila | NCTC 11192 |
| 70101 | Listeria grayi | NCTC 10812 |
| 70029 | Listeria innocua | NCTC 11288 |
| 70030 | Listeria ivanoviisubsp.ivanovii | NCTC 11846 |
| 70188 | Listeria monocytogenes | NCTC 10357 |
| 70085 | Listeria monocytogenes | NCTC 10527 |
| 70060 | Listeria monocytogenes | NCTC 13372 |
| 70031 | Listeria monocytogenes | NCTC 13627 |
| 70148 | Listeria monocytogenes | NCTC 7973 |
| 70102 | Micrococcus luteus | NCTC 2665 |
| 70096 | Micrococcus luteus | NCTC 7743 |
| 70103 | Moraxella (Branhamella) catarrhalis | NCTC 11020 |
| 70104 | Neisseria gonorrhoeae | NCTC 12700 |
| 70074 | Neisseria gonorrhoeae | NCTC 8375 |
| 70164 | Neisseria meningitidis | NCTC 10026 |
| 70189 | Nocardia brasiliensis | NCTC 11294 |
| 70165 | Peptostreptococcus anaerobius | NCTC 11460 |
| 70094 | Plesiomonas shigelloides | NCTC 10360 |
| 70162 | Porphyromonas gingivalis | NCTC 11834 |
| 70134 | Prevotella melaninogenica | NCTC 12963 |
| 70190 | Proteus hauseri | NCTC 4175 |
| 70083 | Proteus mirabilis | NCTC 11938 |
| 70108 | Pseudomonas aeruginosa | NCTC 10332 |
| 70033 | Pseudomonas aeruginosa | NCTC 12903 |
| 70034 | Pseudomonas aeruginosa | NCTC 12924 |
| 70109 | Pseudomonas aeruginosa | NCTC 13359 |
| 70110 | Pseudomonas fluorescens | NCTC 10038 |
| 70035 | Rhodococcus equi | NCTC 1621 |
| 70036 | Saccharomyces cerevisiae | NCTC 10716 |
| 70154 | Salmonella enterica subsp. arizonae | NCTC 8297 |
| 70132 | Salmonella enterica subsp. enterica serovar Abony | NCTC 6017 |
| 70084 | Salmonella enterica subsp. enterica serovar Enteritidis | NCTC 12694 |
| 70037 | Salmonella enterica subsp. enterica serovar Typhimurium | NCTC 12023 |
| 70054 | Salmonella enterica subsp. enterica serovar Typhimurium | NCTC 74 |
| 70121 | Serratia marcescens | NCTC 13382 |
| 70044 | Staphylococcus aureus | NCTC 10788 |
| 70039 | Staphylococcus aureus | NCTC 12493 |
| Shigella flexneri | NCTC 12698 | |
| 70137 | Staphylococcus aureus subsp. aureus | NCTC 10655 |
| 70041 | Staphylococcus aureus subsp. aureus | NCTC 12973 |
| 70040 | Staphylococcus aureus subsp. aureus | NCTC 12981 |
| 70043 | Staphylococcus aureus subsp. aureus | NCTC 13373 |
| 70182 | Staphylococcus aureus subsp. aureus | NCTC 6571 |
| 70202 | Staphylococcus epidermidis | NCTC 11047 |
| 70045 | Staphylococcus epidermidis | NCTC 13360 |
| 70126 | Staphylococcus haemolyticus | NCTC 11042 |
| 70153 | Staphylococcus saprophyticus | NCTC 7292 |
| 70133 | Staphylococcus xylosus | NCTC 11043 |
| 70149 | Stenotrophomonas maltophilia | NCTC 10257 |
| 70046 | Streptococcus agalactiae | NCTC 8181 |
| 70127 | Streptococcus anginosus | NCTC 10713 |
| 70061 | Streptococcus bovis | NCTC 8177 |
| 70062 | Streptococcus mutans | NCTC 10449 |
| 70047 | Streptococcus pneumoniae | NCTC 12977 |
| 70048 | Streptococcus pyogenes | NCTC 12696 |
| 70186 | Streptococcus salivarius subsp. thermophilus | NCTC 12958 |
| 70064 | Streptococcus sanguinis | NCTC 7863 |
| 70144 | Vibrio alginolyticus | NCTC 12160 |
| 70056 | Vibrio parahaemolyticus | NCTC 10903 |
| 70168 | Yersinia enterocolitica subsp. enterocolitica | NCTC 10598 |
| 70050 | Yersinia enterocolitica subsp. enterocolitica | NCTC 12982 |
| 89501 | Aspergillus brasiliensis derived from ATCC 16404 | 1 pellet + 1 rehydrating fluid |
| 89502 | Bacillus cereus derived from ATCC 10876 | 1 pellet + 1 rehydrating fluid |
| 89503 | Bacillus subtilis subsp. spizizenii derived from ATCC 6633 | 1 pellet + 1 rehydrating fluid |
| 89506 | Brevundimonas diminuta derived from ATCC 19146 | 1 pellet + 1 rehydrating fluid |
| 89507 | Burkholderia cepacia derived from ATCC 25416 | 1 pellet + 1 rehydrating fluid |
| 89508 | Candida albicans derived from ATCC 10231 | 1 pellet + 1 rehydrating fluid |
| 89510 | Candida albicans derived from ATCC 2091 | 1 pellet + 1 rehydrating fluid |
| 89513 | Clostridium sporogenes derived from ATCC 11437 | 1 pellet + 1 rehydrating fluid |
| 89514 | Clostridium sporogenes derived from ATCC 19404 | 1 pellet + 1 rehydrating fluid |
| 89516 | Enterobacter aerogenes derived from ATCC 13048 | 1 pellet + 1 rehydrating fluid |
| 89517 | Enterococcus faecalis derived from ATCC 29212 | 1 pellet + 1 rehydrating fluid |
| 89518 | Enterococcus faecalis derived from ATCC 7080 | 1 pellet + 1 rehydrating fluid |
| 89519 | Escherichia coli derived from ATCC 8739 | 1 pellet + 1 rehydrating fluid |
| 89521 | GeoBacillus stearothermophilus derived from ATCC 12980 | 1 pellet + 1 rehydrating fluid |
| 89522 | GeoBacillus stearothermophilus derived from ATCC 7953 | 1 pellet + 1 rehydrating fluid |
| 89523 | Kocuria rhizophila derived from ATCC 9341 | 1 pellet + 1 rehydrating fluid |
| 89524 | LactoBacillus fermentum derived from ATCC 9338 | 1 pellet + 1 rehydrating fluid |
| 89525 | Listeria monocytogenes derived from ATCC 19115 | 1 pellet + 1 rehydrating fluid |
| 89526 | Micrococcus luteus derived from ATCC 4698 | 1 pellet + 1 rehydrating fluid |
| 89527 | Pseudomonas aeruginosa derived from ATCC 27853 | 1 pellet + 1 rehydrating fluid |
| 89528 | Pseudomonas aeruginosa derived from ATCC 9027 | 1 pellet + 1 rehydrating fluid |
| 89530 | Salmonella enterica subsp. enterica serovar Typhimurium derived from ATCC 13311 | 1 pellet + 1 rehydrating fluid |
| 89531 | Salmonella enterica subsp. enterica serovar Typhimurium derived from ATCC 14028 | 1 pellet + 1 rehydrating fluid |
| 89533 | Staphylococcus aureus subsp. aureus derived from ATCC 25923 | 1 pellet + 1 rehydrating fluid |
| 89535 | Staphylococcus aureus subsp. aureus derived from ATCC 6538 | 1 pellet + 1 rehydrating fluid |
| 89534 | Staphylococcus aureus subsp. aureus derived from ATCC 6538P | 1 pellet + 1 rehydrating fluid |
| 89537 | Staphylococcus epidermidis derived from ATCC 12228 | 1 pellet + 1 rehydrating fluid |
| 89538 | Streptococcus pyogenes derived from ATCC 19615 | 1 pellet + 1 rehydrating fluid |
